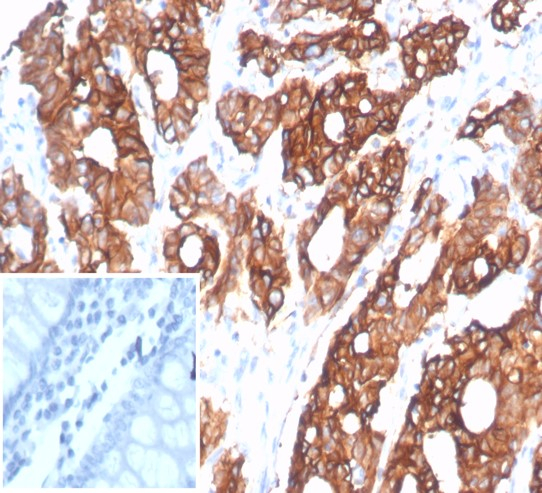
S100 calcium binding protein A14 Antibody (S100A14/7402)

194 results for "S100 calcium binding protein A14" in Products
S100 calcium binding protein A14 Products
S100A14 - S100 calcium binding protein A14
| Applications: | PAGE |
Catalog #:
NBP1-90000PEP
| Applications: | AC |
| Reactivity: | Human |
| Details: | Rabbit IgG Polyclonal |
| Applications: | IHC, ICC/IF |
| Reactivity: | Human |
| Details: | Mouse IgG2a Kappa Monoclonal Clone #S100A14/7401 |
| Applications: | IHC, ELISA |
| Reactivity: | Human |
| Details: | Mouse IgG2a Kappa Monoclonal Clone #S100A14/7401 |
| Applications: | IHC |
| Reactivity: | Human |
| Details: | Mouse IgG2b Kappa Monoclonal Clone #S100A14/7403 |
| Applications: | IHC |
| Reactivity: | Human |
| Details: | Mouse IgG2b Kappa Monoclonal Clone #S100A14/7403 |
| Applications: | IHC |
| Reactivity: | Human |
| Details: | Rabbit IgG Polyclonal |
| Applications: | WB |
Recombinant Monoclonal Antibody
| Reactivity: | Human |
| Details: | Rabbit IgG Kappa Monoclonal Clone #S100A14/9077R |
| Applications: | IHC |
Recombinant Monoclonal Antibody
| Reactivity: | Human |
| Details: | Rabbit IgG Kappa Monoclonal Clone #S100A14/9077R |
| Applications: | IHC |
| Reactivity: | Human |
| Details: | Mouse IgG2b Kappa Monoclonal Clone #S100A14/7402 |
| Applications: | IHC |
| Reactivity: | Human |
| Details: | Mouse IgG2b Kappa Monoclonal Clone #S100A14/7402 |
| Applications: | IHC, ELISA |
Catalog #:
NBP3-21130AFP594
| Reactivity: | Human |
| Details: | Mouse IgG2b Kappa Monoclonal Clone #S100A14/7403 |
| Applications: | IHC, ELISA |
Catalog #:
NBP3-21130AFP488
| Reactivity: | Human |
| Details: | Mouse IgG2b Kappa Monoclonal Clone #S100A14/7403 |
| Applications: | IHC, ELISA |
Catalog #:
NBP3-21128AFP680
| Reactivity: | Human |
| Details: | Mouse IgG2a Kappa Monoclonal Clone #S100A14/7401 |
| Applications: | IHC, ELISA |
Catalog #:
NBP3-24305AFP594
Recombinant Monoclonal Antibody
| Reactivity: | Human |
| Details: | Rabbit IgG Kappa Monoclonal Clone #S100A14/9077R |
| Applications: | IHC, ELISA |
Catalog #:
NBP3-21128AFP594
| Reactivity: | Human |
| Details: | Mouse IgG2a Kappa Monoclonal Clone #S100A14/7401 |
| Applications: | IHC, ELISA |
| Reactivity: | Human, Mouse |
| Details: | Mouse IgG1 Monoclonal Clone #OTI2G9 |
| Applications: | WB |
| Reactivity: | Human, Mouse |
| Details: | Mouse IgG1 Monoclonal Clone #OTI2G9 |
| Applications: | WB |
| Applications: | WB |
| Reactivity: | Human |
| Details: | Mouse IgG2a Kappa Monoclonal Clone #S100A14/7401 |
| Applications: | IHC, ELISA |
Catalog #:
NBP3-21129AFP680
| Reactivity: | Human |
| Details: | Mouse IgG2b Kappa Monoclonal Clone #S100A14/7402 |
| Applications: | IHC, ELISA |
Catalog #:
NBP3-21129AFP555
| Reactivity: | Human |
| Details: | Mouse IgG2b Kappa Monoclonal Clone #S100A14/7402 |
| Applications: | IHC, ELISA |
Catalog #:
NBP3-21128AFP647
| Reactivity: | Human |
| Details: | Mouse IgG2a Kappa Monoclonal Clone #S100A14/7401 |
| Applications: | IHC, ELISA |
Catalog #:
NBP3-21130AFP555
| Reactivity: | Human |
| Details: | Mouse IgG2b Kappa Monoclonal Clone #S100A14/7403 |
| Applications: | IHC, ELISA |

![SDS-PAGE: Recombinant Human S100 calcium binding protein A14 His Protein [NBP1-51039] SDS-PAGE: Recombinant Human S100 calcium binding protein A14 His Protein [NBP1-51039]](https://resources.bio-techne.com/images/products/Recombinant-Human-S100-calcium-binding-protein-A14-Protein-SDS-Page-NBP1-51039-img0001.jpg)
![Immunocytochemistry/ Immunofluorescence: S100 calcium binding protein A14 Antibody [NBP1-90000] Immunocytochemistry/ Immunofluorescence: S100 calcium binding protein A14 Antibody [NBP1-90000]](https://resources.bio-techne.com/images/products/S100-calcium-binding-protein-A14-Antibody-Immunocytochemistry-Immunofluorescence-NBP1-90000-img0012.jpg)




![Western Blot: S100 calcium binding protein A14 Antibody [NBP3-12990] Western Blot: S100 calcium binding protein A14 Antibody [NBP3-12990]](https://resources.bio-techne.com/images/products/S100-calcium-binding-protein-A14-Antibody-Western-Blot-NBP3-12990-img0001.jpg)
![Immunohistochemistry-Paraffin: S100 calcium binding protein A14 Antibody (S100A14/9077R) - Azide and BSA Free [NBP3-24305] -](https://resources.bio-techne.com/images/products/nbp3-24305_rb-s100a14-mab-s100a14-9077r-azide-bsa-free-1312202316331820.jpg)
![Immunohistochemistry-Paraffin: S100 calcium binding protein A14 Antibody (S100A14/9077R) [NBP3-23639] - S100 calcium binding protein A14 Antibody (S100A14/9077R)](https://resources.bio-techne.com/images/products/nbp3-23639_rabbit-s100-calcium-binding-protein-a14-mab-s100a14-9077r-1312202311502947.jpg)

![Western Blot: S100 calcium binding protein A14 Antibody (OTI2G9)Azide and BSA Free [NBP2-73966] Western Blot: S100 calcium binding protein A14 Antibody (OTI2G9)Azide and BSA Free [NBP2-73966]](https://resources.bio-techne.com/images/products/S100-calcium-binding-protein-A14-Antibody-OTI2G9-Azide-and-BSA-Free-Western-Blot-NBP2-73966-img0001.jpg)
![Western Blot: S100 calcium binding protein A14 Antibody (OTI2G9) [NBP2-45659] Western Blot: S100 calcium binding protein A14 Antibody (OTI2G9) [NBP2-45659]](https://resources.bio-techne.com/images/products/S100-calcium-binding-protein-A14-Antibody-2G9-Western-Blot-NBP2-45659-img0001.jpg)
![Western Blot: S100 calcium binding protein A14 Overexpression Lysate [NBL1-15652] Western Blot: S100 calcium binding protein A14 Overexpression Lysate [NBL1-15652]](https://resources.bio-techne.com/images/products/S100-calcium-binding-protein-A14-Overexpression-Lysate-Adult-Normal-Western-Blot-NBL1-15652-img0002.jpg)
